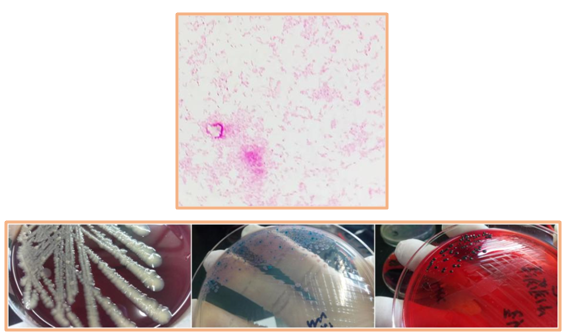

宝宝反复腹泻、高热,原因是…
案例经过
1岁多的吃奶娃的豆豆,半个月来因为拉肚子发烧的缘故,医院没少去,连贴带吃的药换了一遍,正瞅着这两天体温恢复了正常,大便次数也有所减少,看着细心调养的豆宝儿慢慢恢复活力,又变得能吃能睡能玩起来,才把心放肚里的宝爸宝妈,这两天又被揪了起来,豆豆腹泻和发烧的症状突然再次出现,而且较之前更为严重。
入院查体
体温:37.5℃ 心率:120次/分 呼吸:30次/分 体重:12.5Kg
除腹部检查中肠鸣音稍活跃外,余肺部、神经系统、脊柱四肢、头、眼、耳、鼻、心脏检查等阴性。
辅助检查

入院血常规示:WBC/PLT升高,淋巴细胞比值/数量升高(?)

CRP:轻度升高

尿常规:大致正常

双侧血培养48h初报:阴性

入科四项检查HBs-Ab阳性

七项呼吸道病毒检测:阴性

大便常规:阴性
大便轮状/诺如病毒检测:阴性
案例分析
临床角度 腹泻病史+发热+血象(炎性指标)增高:感染性腹泻症较为明确,结合实验室检查部分,大便常规正常与细菌性痢疾经典脓血便的表现相悖,轮状、诺如病毒检测又帮助排除了常见病毒性感染所致腹泻的可能,结合血常规中淋巴细胞增高(细菌内毒素所致继发性升高)的表现,诊断似乎已经呼之欲出。
实验室角度 无论是临检、细菌、生化、免疫的任何一份报告,单独看来似乎都不能给我们提供更多有助于诊断的信息,但如果你日常储备了一些感染性腹泻病原学&临床知识,返过头来看,血培养48小时报阴(病程两周+)+大便常规正常,这些都与伤寒病人的临床体征及实验室检查完美吻合,锁定元凶:只差病原学检查这一part。
病原学检查

大便性状:黄绿色稀糊便

首日接种XLD/BA培养基&沙门志贺液体增菌管
次日,挑取中心产H2S菌落转种CHROMagar/XLD培养基
革兰染色:阴性杆菌(×1000)
BA:灰白色,中等,湿润菌落
CHROMagar:小,圆形,边缘整齐,粉紫色半透明菌落
XLD培养基:较大,中心黑色菌落
(35℃5%CO2 24-48h)

生理盐水自凝试验:阴性
A-F群多价血清试验:阳性
O4抗原血清凝集试验:阳性
Hi抗原血清凝集试验:阳性

诊断血清型符合:O4:Hi
WHO卡夫曼表符合B群 鼠伤寒沙门氏菌

XLD培养基纯菌落配制0.5McF,BDphenix100上机鉴定
沙门氏菌某些种(可信度99%)
治疗与转归

入院后首选头孢噻肟抗感染治疗,第三天患儿体温/大便次数恢复正常。

小结
孤立的看待案例中的每一份报告单,实验诊断方面,很难梳理出头绪,但如果将这些试验结果与伤寒这一疾病的病程发展相结合,腹泻+高热的腹泻病史/病程两周后的血培养阴性/大便培养(鼠伤寒沙门氏菌)/反复出现的发热、腹泻(第二次菌血症)临床表现,临床诊疗-实验室之间其实有着完美的契合关系,典型案例的回顾,既加深了我们对于伤寒这一疾病的认识,也促使我们从病原学诊断的视角,从临床诊疗的视角,甚至从疾病发生发展的视角来更进一步了解手中每一张报告单(包括一些阴性报告)背后的价值。本病治疗上推荐三代头孢(头孢噻肟、头孢曲松、头孢他啶),加酶抑制剂的β内酰胺类(哌拉西林他唑巴坦)为首选方案;碳青霉烯类可作为多重耐药沙门菌属感染的针对性用药。
参考文献
1 https://www.who.int
2 http://www.chinets.com/
3 中华医学会儿科学分会消化学组, 《中华儿科杂志》编辑委员会. 中国儿童急性感染性腹泻病临床实践指南[J]. 中华儿科杂志, 2016, 54(7):483-488.
检验视界网微信平台独家首发,转载请注明来源及作者!

